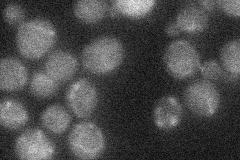
YDR421W
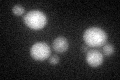
YDR421W

View description
Zinc finger transcriptional activator of the Zn2Cys6 family; activates transcription of aromatic amino acid catabolic genes in the presence of aromatic amino acids
Localization:
Intensity:
Fold change:
Significance:
-
C’ GFP library in SD

nucleus16.97 -
N' NOP1pr-GFP in SD

below threshold13.4049 -
N' TEF2pr-mCherry in SD

nucleus29.422 -
N' NATIVEpr-GFP in SD
below threshold19.7382 -
N' TEF2pr-VC and Cyto-VN in SD

nucleus23.1146 -
C’ GFP library in SD+DTT
nucleus19.581.15No -
C’ GFP library in SD+H2O2

nucleus16.960.99No -
C’ GFP library in Starvation Media

nucleus18.391.08No -
C’ GFP library on the background of Pup2-DaMP

nucleus -
C’ GFP library on the background of CCT mutant

nucleus16.96620.999157No
